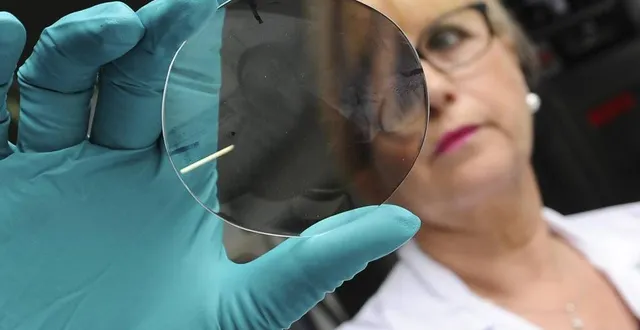
photo voici peu, le site fabriquait 3 000 verres correcteurs par jour. &copy; archives le maine libre hervé petitbon

|
Allonnes. Le laboratoire Essilor relocalisé en région parisienne ?... |
1
1
Voici peu, le site fabriquait 3 000 verres correcteurs par jour. © Archives Le Maine Libre Hervé Petitbon
Le laboratoire Essilor basé à Allonnes qui fait travailler près de 70 personnes est appelé à converger, avec d’autres sites français, sur un pôle industriel central situé près de Paris.
Voici une mauvaise nouvelle pour Allonnes en général et la zone du Vivier en particulier. Selon la revue spécialisée Acuité, on apprend qu’à l’horizon 2023 le groupe Essilor a décidé de regrouper les activités de plusieurs sites en un seul et même pôle. Ce pôle sera situé à Antony en région parisienne et parmi les sites transférés se trouve celui d’Allonnes…
Essilor investit 40 millions d’euros dans la création d’un laboratoire d’excellence en Francehttps://t.co/mt2YZrZedF #verres #lunettes #France #opticiens pic.twitter.com/UQGhjGyhaM
— L'OL [MAG] (@OL_Magazine) October 7, 2020
70 personnes à Allonnes
En fait le projet représente un investissement de 40 millions d’euros et concerne le regroupement des laboratoires d’Allonnes, de Vaulx-en-Velin, du centre de distribution de Châlons-en-Champagne et de l’activité montage de Toulouse.
Tout cela sera rassemblé dans une unité installée dans les Hauts-de-Seine. À noter que le laboratoire Essilor d’Allonnes fait travailler près de 70 personnes et a pour spécialité la fabrication continue de verres correcteurs, solaires ou non. Une fabrication 24 heures/24 qui permet d’assurer la livraison chez les opticiens sous 48 heures.







